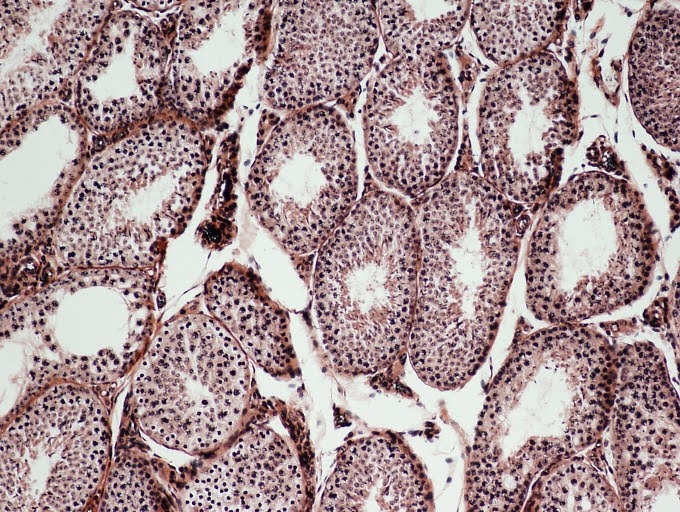
<p><span><span>Identify the pictured endocrine organ.</span></span></p>
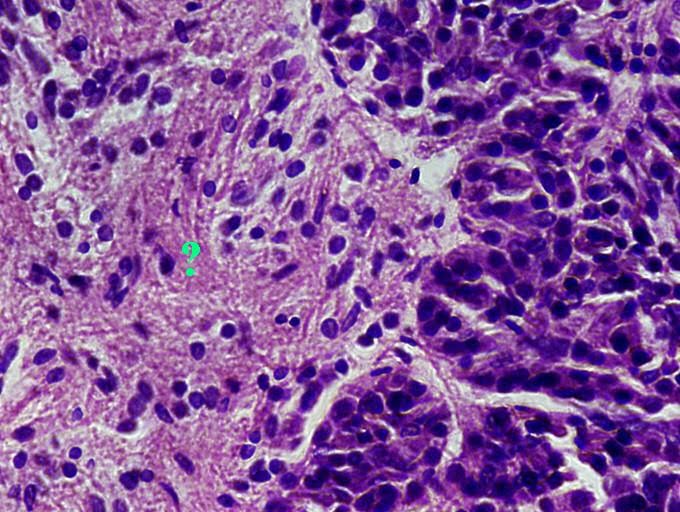
<p><span><span>Identify the indicated region of the pituitary gland.</span></span></p>
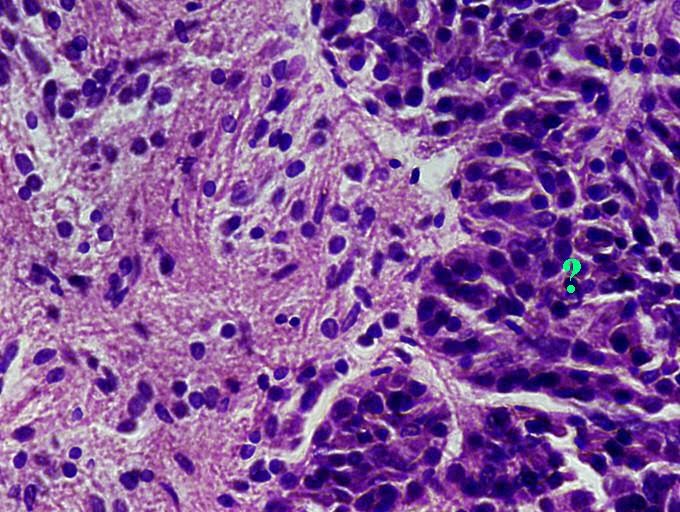
<p><span><span>Identify the indicated region of the pituitary gland.</span></span></p>

1/234
Looks like no tags are added yet.
Name | Mastery | Learn | Test | Matching | Spaced | Call with Kai |
|---|
No analytics yet
Send a link to your students to track their progress
The right atrium empties blood into which chamber of the heart?
Right ventricle
Which heart valve separates the aorta from the left ventricle?
Aortic valve
The left atrium empties blood into which chamber of the heart?
Left ventricle
Which heart valve separates the right ventricle from the pulmonary artery?
Pulmonary valve
The left ventricle empties blood into which blood vessel?
Aorta
Which heart valve separates the left atrium from the left ventricle?
Bicuspid valve
Which heart valve separates the right atrium from the right ventricle?
Tricuspid valve
The pulmonary vein empties blood into which chamber of the heart?
Left atrium
In a normal adult, does blood passing through the pulmonary semilunar valve have a high oxygen concentration or a low oxygen concentration?
Low oxygen
In a normal adult, does blood passing through the bicuspid valve have a high oxygen concentration or a low oxygen concentration?
High oxygen
In a normal adult, does blood passing through the tricuspid valve have a high oxygen concentration or a low oxygen concentration?
Low oxygen
In a normal adult, does blood passing through the aortic semilunar valve have a high oxygen concentration or a low oxygen concentration?
High oxygen

Identify the indicated layer.
visceral pericardium

Identify the indicated layer.
Myocardium

Identify the indicated region.
Right ventricle

Identify the indicated region.
Left ventricle

Right atrium

Pulmonary trunk

left atrium

superior vena cava

ligamentum arteriosum

inferior vena cava

aortic arch

Papillary muscle

Pulmonary veins

Tricuspid valve

Fossa ovalis

pulmonary semilunar valve

aortic semilunar valve

chordae tendineae

interventricular septum

bicuspid valve

A

B

AB

O
If you want to attempt a specific diagnosis for a person with a blood disorder, would you order a differential WBC count or a total WBC count?
Differential wbc count
The chemical [x1] is added to hematocrit capillary tubes to prevent clotting.
Heparin
Activated monocytes are calle [x1].
Macrophages
The most abundant leukocytes in normal blood are [x1].
Neutrophils
The least abundant leukocytes in normal blood are [x1].
Basophils
[x1] are fragments of megakaryocytes and are instrumental in blood clotting.
Platelets
The leukocytes known as [x1] have granules that stain red with Wright's stain and are responsible for killing parasitic worms.
Eosinophils
The formed elements known as [x1] are shaped like bi-concave discs and are responsible for carrying oxygen and carbon dioxide in the blood.
Erythrocytes
You perform a hematocrit measurement on a sample of blood from a healthy male and a sample from a male with aplastic anemia. Which sample do you expect to have the higher hematocrit?
Healthy male
You perform a hematocrit measurement on a sample of blood from a healthy male and a sample from a healthy female. Which sample do you expect to have the higher hematocrit?
Healthy male
You perform a hematocrit measurement on a sample of blood from a healthy male and a sample from a male with iron deficiency anemia. Which sample do you expect to have the lower hematocrit?
iron deficiency anemia male
You perform a hematocrit measurement on a sample of blood from a healthy female and a sample from a female with aplastic anemia. Which sample do you expect to have the lower hematocrit?
Aplastic female
You perform a hematocrit measurement on a sample of blood from a healthy male from Boston and a sample from a healthy male from Denver. Which sample do you expect to have the higher hematocrit?
Denver

Identify the indicated formed element of the blood.
Basophil

Identify the indicated formed element of the blood.
Monocyte

Identify the indicated formed element of the blood.
Eosinophil

Identify the indicated formed element of the blood.
Lymphocyte

Identify the indicated formed element of the blood.
Neutrophil

Identify the indicated formed element of the blood.
Erythrocyte
Deficiency of vitamin [x1] results in pernicious anemia.
B12
[x1] anemia is inherited as a recessive trait, most commonly by people of african descent.
Sickle cell
Blank
Blank
Blank
Blank
This question refers to the Hormone Replacement portion of the Endocrine PhysioEx exercise. Was the weight of the uterus in the control rat higher, lower, or the same as the weight of the uterus of the rat treated with estrogen?
Lower
This question refers to the Insulin and Diabetes portion of the Endocrine PhysioEx exercise. Prior to the insulin injection, is the blood glucose concentration of the control rat higher, lower, or the same as the blood glucose concentration of the Alloxan treated rat?
Lower
This question refers to the Metabolism portion of the Endocrine PhysioEx exercise. Which rat did not respond to TSH?
Thyroidectomized rat
This question refers to the Hormone Replacement portion of the Endocrine PhysioEx exercise. What effect did estrogen have on uterine weight?
Increased
This question refers to the Insulin and Diabetes portion of the Endocrine PhysioEx exercise. After the insulin injection, is the blood glucose concentration of the Aloxan treated rat higher, lower, or the same as the blood glucose concentration of the Alloxan treated rat prior to insulin injection?
Lower
This question refers to the Metabolism portion of the Endocrine PhysioEx exercise. Did the metabolic rate of the thyroidectomized rat increase in response to thyroxine?
Yes
This question refers to the Metabolism portion of the Endocrine PhysioEx exercise. Did the metabolic rate of the thyroidectomized rat increase in response to propylthiouracil?
No
This question refers to the Metabolism portion of the Endocrine PhysioEx exercise. How did the baseline metabolic rate of the control rat compare to the metabolic rates of the two experimental rats?
Higher
This question refers to the Metabolism portion of the Endocrine PhysioEx exercise. How did the baseline metabolic rates of the experimental rats compare to the metabolic rate of the control rat?
Lower
This question refers to the Insulin and Diabetes portion of the Endocrine PhysioEx exercise. Prior to the insulin injection, what specific cells were destroyed in the experimental rat by Alloxan injections?
Beta cells
This question refers to the Insulin and Diabetes portion of the Endocrine PhysioEx exercise. Before beginning this experiment, we measured the absorbance or optical density of a series of known concentrations of glucose in a spectrophotometer. What do we call the graph we obtained from this procedure?
Glucose standard curve
This question refers to the Metabolism portion of the Endocrine PhysioEx exercise. Did the metabolic rate of the control rat increase in response to propylthiouracil?
No
This question refers to the Metabolism portion of the Endocrine PhysioEx exercise. Did the metabolic rate of the hypophysectomized rat increase in response to propylthiouracil?
No
This question refers to the Metabolism portion of the Endocrine PhysioEx exercise. Did the metabolic rate of the hypophysectomized rat increase in response to thyroxine?
Yes

Name a hormone produced by the indicated endocrine gland.
Calcitonin

Name a hormone produced by the indicated endocrine gland.
parathyroid hormone

Name a hormone produced by the indicated region of the adrenal gland.
Epinephrine

Identify the indicated structure within the ovary.
Oocyte

Identify the indicated structure within the ovary.
Antral follicle

Identify the indicated structure within the ovary.
Primary follicle

Identify the indicated structure within the ovary.
Corpus luteum

What hormone producing cells are found in the indicated regions?
interstitial cells

Identify the indicated region of the pancreas
pancreatic islets

name a hormone produced by the indicated region of the pancreas.
Insulin

What hormone is produced by the cells found in the indicated region?
Testosterone
Identify the pictured endocrine organ.
Testis
Identify the indicated region of the pituitary gland.
posterior pituitary
Identify the indicated region of the pituitary gland.
anterior pituitary

What hormone producing cells are found in the indicated region within the ovary?
Granulosa cells

Name a hormone producing cells are found in the indicated region within the ovary?
Estrogen

Name a hormone producing cells are found in the indicated region within the ovary?
Progesterone

Identify the indicated layer of the adrenal gland.
zona glomerulosa

Identify the indicated layer of the adrenal gland.
zona reticularis

Identify the indicated layer of the adrenal gland.
zona fasciculata

Identify the indicated layer of the adrenal gland.
Medula

Identify the indicated layer of the adrenal gland.
Capsule
Which anterior pituitary hormone controls secretions by the thyroid gland?
thyroid stimulating hormone
Which hormone is released in response to low levels of circulating calcium?
parathyroid hormone
Which hormone is released in response to low levels of circulating glucose?
Glucagon
Which anterior pituitary hormone controls secretions by the adrenal cortex?
adrenocorticotropic hormone
Which hormone is released in response to high levels of circulating glucose?
Insulin